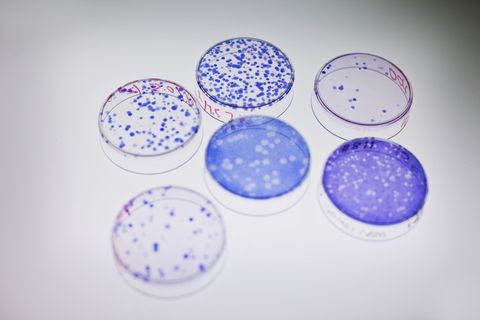

Center for Environmental Sciences and Engineering
Center for Open Research Resources and Equipment
Clinical Research Center
College of Agriculture, Health, and Natural Resources
College of Engineering
Department of Chemistry
Department of Marine Sciences
Department of Molecular & Cell Biology
Department of Nutritional Sciences
Department of Physiology and Neurobiology
Information Technology Services
Innovation Partnership Building
Institute for Collaboration of Health, Intervention, and Policy
Institute for Systems Genomics
Institute of Materials Science
Other UConn Health Cores
School of Nursing
Shared Management Resources
UConn Center for Aging
UConn Health Center Research Advisory Council Cores

CCAM Microscopy User Facility

Cell and Genome Engineering Core

Center for Genome Innovation (CGI)

Center for Mouse Genome Modification (CMGM)

Central Electron Microscopy Facility (CEMF)

Computational Biology Core (CBC)

Flow Cytometry

High Performance Computing (HPC)

JAX Single Cell Biology Laboratory (SCBL)

MicroCT Imaging Facility

Molecular Core Facility

NMR Structural Biology & Biophysical Core Facility